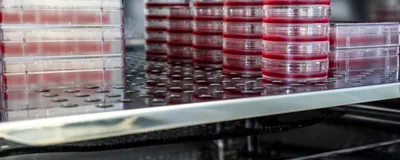
Various cell culture containers, including dishes and flasks, filled with media and stacked inside an incubator. Various cell culture containers, including dishes and flasks, filled with media and stacked inside an incubator.

Cell culture is a fundamental technique for life science applications ranging from research to industrial manufacturing. Finding the optimal conditions for specific cell types to grow and thrive is a difficult task that scientists routinely face. Researchers must also contend with external obstacles such as contamination, workflow inefficiencies, and the logistics of scaling.
Download this compendium to learn more about tackling cell culture challenges big and small, from learning about bioprocessing and 3D cell culture to fine-tuning established protocols.
Here is a look at what’s inside
- Article: An Introduction to Bioprocessing
- Article: Understanding the 3D Cell Culture Revolution
- White Paper: Solving Common Challenges of Mammalian Cell Shake Flask Culture
- White Paper: Preventing Contamination in CO2 Incubator Shakers